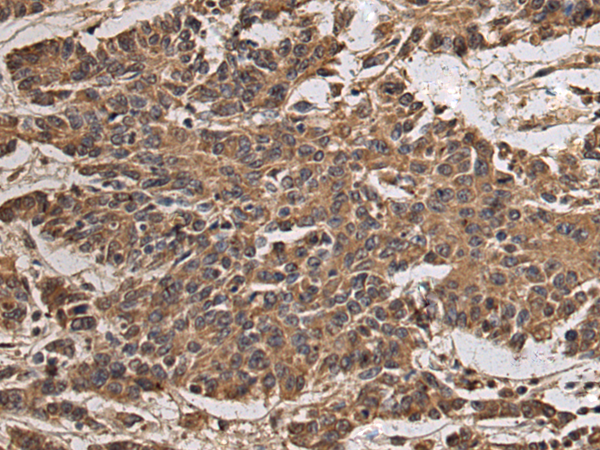
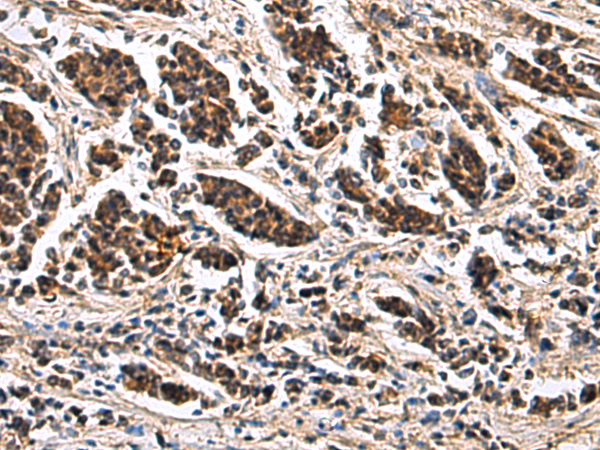

-
分类: 科研抗体货号: P10420别名: KIR1.2; KIR4.1; SESAME; BIRK-10; KCNJ13-PEN应用: IHC反应种属: Human, Mouse, Rat
-
分类: 科研抗体货号: P10404别名: HE; B3-1; CASP; CYBR; CYTHIP; PSCDBP应用: IHC反应种属: Human, Mouse, Rat
-
分类: 科研抗体货号: P10437别名:应用: WB,IHC反应种属: Human, Mouse
-
分类: 科研抗体货号: P10419别名: ZLYAR; ZC2HC2应用: WB,IHC反应种属: Human
-
分类: 科研抗体货号: P10429别名: TLL; ASD6应用: IHC反应种属: Human, Mouse
-
分类: 科研抗体货号: P10436别名: GIIB; PCLD; PLD1; G19P1; PCLD1; PKCSH; AGE-R2; VASAP-60应用: WB,IHC反应种属: Human, Mouse
-
分类: 科研抗体货号: P10417别名: CYI; CYC1; CCNI1应用: IHC反应种属: Human, Mouse
-
分类: 科研抗体货号: P10428别名: SPS; SELD; SPS1应用: IHC反应种属: Human, Mouse
-
分类: 科研抗体货号: P10435别名: PML1; PMRED应用: WB,IHC反应种属: Human, Mouse, Rat
-
分类: 科研抗体货号: P10416别名: ARC41; PLTEID; p40-ARC; p41-ARC应用: WB,IHC反应种属: Human, Mouse, Rat

鄂公网安备42018502007531号
鄂公网安备42018502007531号

